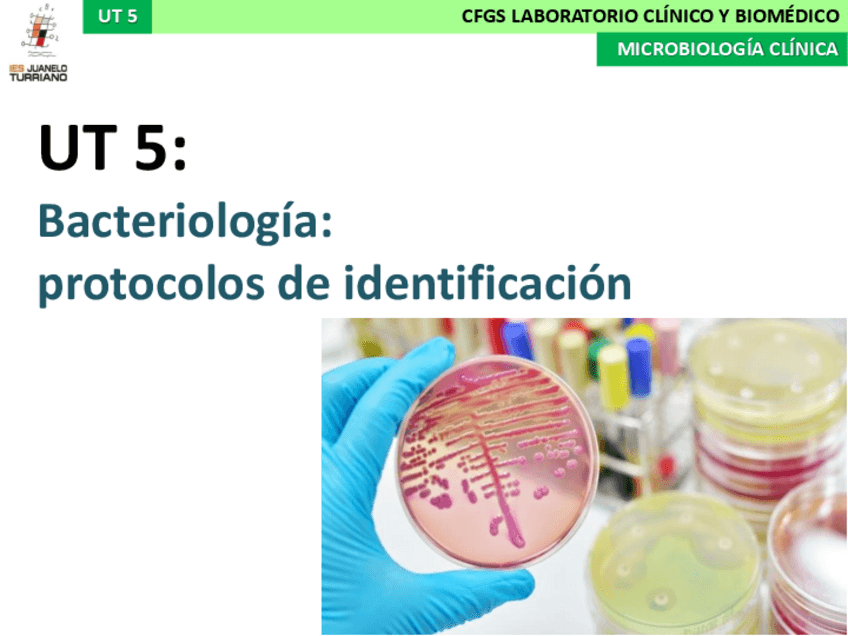

@Silvia_Redondo
Bio: Mi nombre es SILVIA, tengo 22 años. Estudiante de FP superior Laboratorio Clínico y Biomédico.
52 Publicaciones
566 Interacciones
9 Seguidores
0 Siguiendo
Lista de publicaciones de Silvia_Redondo
apuntes
-
SELECTIVIDAD 2022
Bachillerato de Ciencias y Tecnología
apuntes
-
Apuntes Biología Molecular
He publicado nuevos apuntes de Biología molecular y citogenética: Apuntes Biología Molecular
apuntes
-
MICROBIOLOGÍA
He publicado nuevos apuntes de Microbiología clínica: MICROBIOLOGÍA
apuntes
-
BACTERIOLOGIA
He publicado nuevos apuntes de Microbiología clínica: BACTERIOLOGIA
He publicado nuevos apuntes de Microbiología clínica: Medios-mas-habitualesesquema-resumen.pdf
apuntes
-
Apuntes INMUNODIAGNÓSTICO
He publicado nuevos apuntes de Técnicas de inmunodiagnóstico: Apuntes INMUNODIAGNÓSTICO
He publicado nuevos apuntes de Biología molecular y citogenética: EL-CICLO-CELULAR-1.pdf
apuntes
-
HEMATOLOGÍA
He publicado nuevos apuntes de Técnicas de análisis hematológico: HEMATOLOGÍA